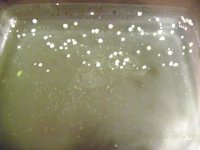
OMG-3.jpg

-
Members of the previous forum can retrieve their temporary password here, (login and check your PM).
You are using an out of date browser. It may not display this or other websites correctly.
You should upgrade or use an alternative browser.
You should upgrade or use an alternative browser.
Trying to improve Acacia information
- Thread starter nen888
- Start date
Migrated topic.
bah i just spilled a shitload of acacia floribunda soup on the floor. forgot that I had a bag of phyllodes from a council planted floribunda from ages ago.. these ones looked much more like what I was looking for too. 12cm phyllodes, 3 main veins, quite hairy on the stems, no basal gland, and very papery feeling phyllodes.. 0.5cm wide
i've got photos but they are terrible quality..
fortunately i was able to recover lots of it through absorbing in paper towells and squeezing back into the pot
oh and also boiling some acacia iteaphylla at the moment.. will post results
i've got photos but they are terrible quality..
fortunately i was able to recover lots of it through absorbing in paper towells and squeezing back into the pot
oh and also boiling some acacia iteaphylla at the moment.. will post results
..Growpen you wrote
it was probably not as relevant for you Growpen back then as you hadn't looked for it as much, but a lot of variation is allowed..this is also why pods/flowers are crucial for certain ID of most acacias..between all the sub-forms of acuminata and subspecies burkitti, theres are wide range geographically of the Rasberry Jam Tree 'family'..
one may well be close to you and your family, Growpen..your visual acuity to plant forms must be increasingly heightened since going in search of these trees.. ..
..
.
..remember this chart of acuminata sub-forms and close genetic relatives, back on p.19..?The acumanata don't seem to show the curled tips in the photo above. I've seen these near my home.
it was probably not as relevant for you Growpen back then as you hadn't looked for it as much, but a lot of variation is allowed..this is also why pods/flowers are crucial for certain ID of most acacias..between all the sub-forms of acuminata and subspecies burkitti, theres are wide range geographically of the Rasberry Jam Tree 'family'..
one may well be close to you and your family, Growpen..your visual acuity to plant forms must be increasingly heightened since going in search of these trees..
 ..
...
..bricklaya..i know that 'spilt the tea' feeling as well..happens sometimes with instinctively exciting potions..oh well..
floribunda and maidenii are coming into flower in many areas now, making it a good time to properly ID..
the pods follow flowering around 1-3 months after (unless there were no other trees to mate with)
.
..this really sounds like the right description of typical floribunda..it was planted a lot by councils in victoria, and they say that's what it is it probably is..at least you know where they were..i guess the larger leaf photo of floribunda on p10 is atypical, and the more recent and other photos are the common form..the slight sparseness and shorter length of the flower (in all forms) are also an important indicator..bah i just spilled a shitload of acacia floribunda soup on the floor. forgot that I had a bag of phyllodes from a council planted floribunda from ages ago.. these ones looked much more like what I was looking for too. 12cm phyllodes, 3 main veins, quite hairy on the stems, no basal gland, and very papery feeling phyllodes.. 0.5cm wide
floribunda and maidenii are coming into flower in many areas now, making it a good time to properly ID..
the pods follow flowering around 1-3 months after (unless there were no other trees to mate with)
.
yeah i compared it with the maidenii I got the other day.. in comparison the maidenii's phyllodes are huge! always saw that tree from a distance and assumed it was floribunda due to the flowers but looks like I was wrong. One thing i have noticed is that maidenii flowers seem a little more intact than floribunda's?
well I do hope I get something out of these.. its been quite a long time in the making this relationship with myself and floribunda. I will be stoked to see some alkaloids.
off to warrendyte hopefully on the weekend to have a look for some mucronata too. Do you have info on alkaloid content of the regular mucronata? or just the longifolia subs?
Oh! And one more thing.. I noticed you wholeheartedly recommending methanol or ethanol soaking for the acid boil? Do you think methylated spirits could suffice? I am not sure where to get ethanol..
cheers
well I do hope I get something out of these.. its been quite a long time in the making this relationship with myself and floribunda. I will be stoked to see some alkaloids.
off to warrendyte hopefully on the weekend to have a look for some mucronata too. Do you have info on alkaloid content of the regular mucronata? or just the longifolia subs?
Oh! And one more thing.. I noticed you wholeheartedly recommending methanol or ethanol soaking for the acid boil? Do you think methylated spirits could suffice? I am not sure where to get ethanol..
cheers
I will also add that these phyllodes and stems were from the same stand of flori's that my last non active bark was from.. although the bark was from chopped down trees which had been poured on by rain a few days earlier. perhaps the rain could have effected the phyllodes too (which were from a huge live tree about 25 meters away). i guess time will tell.
Acacia Iteaphylla smells absolutely beautiful when boiled... kinda like camomile tea. was tempted to dip my finger in just to see if it was bitter.. and got the chalkiness one gets from an unripe banana .. very bitter, hopefully indicating some kind of alkaloid present
.. very bitter, hopefully indicating some kind of alkaloid present
Acacia Iteaphylla smells absolutely beautiful when boiled... kinda like camomile tea. was tempted to dip my finger in just to see if it was bitter.. and got the chalkiness one gets from an unripe banana
 .. very bitter, hopefully indicating some kind of alkaloid present
.. very bitter, hopefully indicating some kind of alkaloid present..reminder, new acacia analysis results, see prev. page..and INDEX of this thread here..
bricklaya wrote:
..but some people have actually reported better results from A. floribunda phyllodes/twig than bark..really, apart from being more taxing to the tree, bark, even branch bark, is a bigger hassle to grind up etc..one of my main objectives and practices with the trees has been to find good phyllode species..makes testing much easier..

.
bricklaya wrote:
..if the bark has been allowed to die/dry on the plant, even after a short time it can have no alkaloid..(if collected with alkaloid and stored it is fine for a few years)..rain (& flowering) lower yields..I will also add that these phyllodes and stems were from the same stand of flori's that my last non active bark was from.. although the bark was from chopped down trees which had been poured on by rain a few days earlier. perhaps the rain could have effected the phyllodes too (which were from a huge live tree about 25 meters away)
..but some people have actually reported better results from A. floribunda phyllodes/twig than bark..really, apart from being more taxing to the tree, bark, even branch bark, is a bigger hassle to grind up etc..one of my main objectives and practices with the trees has been to find good phyllode species..makes testing much easier..
..check the INDEX or p5 LIST for info, there's a cpl of alk +ve for the other varities, and a -ve..methylated spirits in aus is 95-98% ethanol, the remainder is volatile (means evaporates to nothing) ..still good to be discrete about how much you purchase, IYKWIM..Do you have info on alkaloid content of the regular mucronata? or just the longifolia subs?
Oh! And one more thing.. I noticed you wholeheartedly recommending methanol or ethanol soaking for the acid boil? Do you think methylated spirits could suffice? I am not sure where to get ethanol..
..there are certainly some wonderful fragrances in these plants..sounds nice..Acacia Iteaphylla smells absolutely beautiful when boiled... kinda like camomile tea. was tempted to dip my finger in just to see if it was bitter.. and got the chalkiness one gets from an unripe banana .. very bitter, hopefully indicating some kind of alkaloid present

.
cave paintings
Rising Star
Hey nen and other acacia-philes! Thanks for gathering and sharing all this great information. I've been going over this thread for the past few days nonstop after I have noticed the massive amount of acacias where I live.
So far I THINK I have successfully ID'd a.cultriformis, a.cyclops, and a.redolens. They're truly popping up every where I go, the seed pods and remaining flowers are giving them away.
There are a few unidentified ones I will post up here soon as well.
I did a quick STB on one of the unidentified ones that at the time I thought was confusa but after reading more I am only left in confusion. I did the STB on bark and phylodes (about 30-40 grams in total). Freeze precipitating now.
I was wondering if you had more info on a.redolens. I searched earlier and saw the Trout's notes reference of it being suspected to contain tryptamines. Was wondering if you had any info not mentioned earlier in this thread though as it grows everywhere around here along with the rampant a.cyclops.
So far I THINK I have successfully ID'd a.cultriformis, a.cyclops, and a.redolens. They're truly popping up every where I go, the seed pods and remaining flowers are giving them away.
There are a few unidentified ones I will post up here soon as well.
I did a quick STB on one of the unidentified ones that at the time I thought was confusa but after reading more I am only left in confusion. I did the STB on bark and phylodes (about 30-40 grams in total). Freeze precipitating now.
I was wondering if you had more info on a.redolens. I searched earlier and saw the Trout's notes reference of it being suspected to contain tryptamines. Was wondering if you had any info not mentioned earlier in this thread though as it grows everywhere around here along with the rampant a.cyclops.
update.. didn't pull any spice from the floribunda phyllodes and stems
although they were months old and had been sitting outside loosely in a bag that wasn't airtight, and as I said before were harvested just days after heavy rain.. so these factors could have effected the outcome. hmmm
although they were months old and had been sitting outside loosely in a bag that wasn't airtight, and as I said before were harvested just days after heavy rain.. so these factors could have effected the outcome. hmmm
By the way nen.. just wanna say a huge thanks for this thread.. You've got me absolutely hooked on researching Acacias!
quick question.. I happen to know of the location of a Burkitti down here.. though it is one I should leave alone due to reasons I won't say publicly on here... but I was thinking I could maybe collect a few seeds from it and have a stab at growing my own. do you know what season seeds would be collectable?
quick question.. I happen to know of the location of a Burkitti down here.. though it is one I should leave alone due to reasons I won't say publicly on here... but I was thinking I could maybe collect a few seeds from it and have a stab at growing my own. do you know what season seeds would be collectable?
^..thanks bricklaya..burkittii should put out seeds around july-sept., after flowering..it's so prolific in some inland areas of SA and NSW that we can only assume it's tough and hardy..
& greetings cave paintings ! good to hear from you..i'm afraid i don't have much info at this stage on A. redolens..it is suspected of 'poisoning' cattle in Arizona (like some Phalaris sp)..a member of the Acacia Study Group (of the Society for Growing Aus plants) wrote in their newsletter:
..there is much still to learn about this 1200+ member genus..
& greetings cave paintings ! good to hear from you..i'm afraid i don't have much info at this stage on A. redolens..it is suspected of 'poisoning' cattle in Arizona (like some Phalaris sp)..a member of the Acacia Study Group (of the Society for Growing Aus plants) wrote in their newsletter:
..no one had any further info..it's native to southern WA..I did refer the question to Dr Claude Culvenor (an APS member who was
formerly Chief Research Scientist at the
CSIRO Division of Organic Chemistry), but he was not
aware of any reports specific to A. redolens. I mentioned to
Claude the well known characteristic of A. redolens in
producing a soapy lather when the leaves are rubbed with
water, and asked whether this might be an indicator of any
particular type of chemical. Claude has advised that this is
characteristic of cyanogenetic glycosides but generally these
are regarded as non-toxic – although on the other hand,
animals are sometimes thought to suffer cyanide poisoning
from breakdown of the glycoside in the gut and possibly
eating more than a usual amount of the plant.
Can any Study Group member comment further on this
question?
..there is much still to learn about this 1200+ member genus..
..an afterword on the recent Acacia analysis by endlessness,
firstly, after checking with the person who extracted the narrow phyllode A. acuminata, they soaked the material in ethanol/dilute acetic acid 50:50 for several hours prior to boiling..followed by NaOH, extracted into xylene, one pull..
this method evidently was efficient and clean (almost an understatement)..i think all that essentially needs to be known regarding extraction has been covered in this thread by now..the real interest for me lies in what's in these interesting lifeforms..
..second, the juvenile A. mucronata extractions are one of the most interesting 'tryptamine' profiles of a plant which doesn't contain any DMT (there may be traces) that i've seen..as i mentioned in the analysis thread, phyllodes of juvenile/young A. phlebophylla tested once as containing mainly tryptamine & some ß-carbs ['J.J.' 2009]..adult plants (3-5 years+) of both mucronata (in 1 test) and phlebophylla (1-2 tests) contained DMT..so the variance could be an age thing, or of course seasonal/individual..
the extracts (essentially apparently NMT, tryptamine, 2MTHBC, harmine and other interesting traces) have been bioassyed by vapor, and had not unpleasant entheogenic effects lasting approx. 45-60 mins, though not very visual..the other tryptamines (& of course betacarbolines) are not without there own modes of potentially therapeutic activity..
..NMT i've covered before, but tryptamine is even less understood..from very limited experience with multialkaloid extracts which had a lot of tryptamine, and from the very limited data on it, i suspect (above a dosage) elicits a fast acting state of 'tryptamine heightened sensory awareness', a bit like NMT, but of an even less visual nature, and likely to induce possible body tremors..a good source has mentioned that apparently Stephen Szára (who first scientifically described the effects of DMT, by injection in 1956 in Hungary) injected tryptamine in 'large doses' in the late 50s and found it to be a 'very fast acting psychedelic'..still can't access the reference..
now if the African A. nilotica (or at least the Kenyan variety) does contain 'harmane derivatives' (ßcarbs) and tryptamine [see refs], this could explain the apparent 'stimulation' and tendency to move 'aggressively' reported by anthropologists of the Masai ceremonial drink made from A. nilotica bark, and brought up by beautifulsorrow on p21#411..i've discussed oral activity elsewhere
the so far repeated finding in A. obtusifolia of small amounts of 3-methyl-quinoline (of unknown toxicity) suggests that this species is slightly more 'odd' than many..this needs further work.. the synchronicity of the 2nd sample also, like mucronata, containing trace harmine is odd, but i can't see how any contamination could have occurred..this is from a not so common form which a botanist i once queried agreed was almost taxonomically the same as forms of mucronata..i have seen several A. obtusifolia extracts which contained apparently no DMT, but had milder activity..
so i think we are seeing a kind of complex between a few related species..
we should remember these species have only been tested a few times or once (meaning from one location/individual or time)..the whole question of Acacia variability is still very open..
..certainly, growers and horticulturalists take note, the narrow phyllode forms of A. acuminata seem (from multiple anecdotal/underground sources) to be very consistent..and the particular specimen tested has about the 'cleanest' dmt profile of a plant i've seen, hence it is a potential reference if the reliability bares out..it should tolerate down to about Minus 8 degrees C, maybe down to minus 10 as some australian species growing in Europe can handle..
.
ps. regarding Growpen's non-dmt alkaloid from the acacia which isn't acuminata (on p24 #479)..by checking for lists of colour reactions to reagents, we can have aguess at the class of alkaloid..for instance, with Ehrlich's i believe PEAs turn yellow-green..tryptamines blue-purple..also, Growpen..the acuminata narrow leaf pictured p28 here does display a slight curving or bent tendency of some phyllodes, though not as actutely curved as the 'typical variant' of A. acuminata, which is really what has been referred to earlier as a 'Species Complex'..
..enlightening research and study, all 'acacia-loving-nexians', to borrow Spice Sailor's phrase..
.
below, Masai men's ceremony, with Acacia nilotica (and orally active brew)..
firstly, after checking with the person who extracted the narrow phyllode A. acuminata, they soaked the material in ethanol/dilute acetic acid 50:50 for several hours prior to boiling..followed by NaOH, extracted into xylene, one pull..
this method evidently was efficient and clean (almost an understatement)..i think all that essentially needs to be known regarding extraction has been covered in this thread by now..the real interest for me lies in what's in these interesting lifeforms..
..second, the juvenile A. mucronata extractions are one of the most interesting 'tryptamine' profiles of a plant which doesn't contain any DMT (there may be traces) that i've seen..as i mentioned in the analysis thread, phyllodes of juvenile/young A. phlebophylla tested once as containing mainly tryptamine & some ß-carbs ['J.J.' 2009]..adult plants (3-5 years+) of both mucronata (in 1 test) and phlebophylla (1-2 tests) contained DMT..so the variance could be an age thing, or of course seasonal/individual..
the extracts (essentially apparently NMT, tryptamine, 2MTHBC, harmine and other interesting traces) have been bioassyed by vapor, and had not unpleasant entheogenic effects lasting approx. 45-60 mins, though not very visual..the other tryptamines (& of course betacarbolines) are not without there own modes of potentially therapeutic activity..
..NMT i've covered before, but tryptamine is even less understood..from very limited experience with multialkaloid extracts which had a lot of tryptamine, and from the very limited data on it, i suspect (above a dosage) elicits a fast acting state of 'tryptamine heightened sensory awareness', a bit like NMT, but of an even less visual nature, and likely to induce possible body tremors..a good source has mentioned that apparently Stephen Szára (who first scientifically described the effects of DMT, by injection in 1956 in Hungary) injected tryptamine in 'large doses' in the late 50s and found it to be a 'very fast acting psychedelic'..still can't access the reference..
now if the African A. nilotica (or at least the Kenyan variety) does contain 'harmane derivatives' (ßcarbs) and tryptamine [see refs], this could explain the apparent 'stimulation' and tendency to move 'aggressively' reported by anthropologists of the Masai ceremonial drink made from A. nilotica bark, and brought up by beautifulsorrow on p21#411..i've discussed oral activity elsewhere
the so far repeated finding in A. obtusifolia of small amounts of 3-methyl-quinoline (of unknown toxicity) suggests that this species is slightly more 'odd' than many..this needs further work.. the synchronicity of the 2nd sample also, like mucronata, containing trace harmine is odd, but i can't see how any contamination could have occurred..this is from a not so common form which a botanist i once queried agreed was almost taxonomically the same as forms of mucronata..i have seen several A. obtusifolia extracts which contained apparently no DMT, but had milder activity..
so i think we are seeing a kind of complex between a few related species..
we should remember these species have only been tested a few times or once (meaning from one location/individual or time)..the whole question of Acacia variability is still very open..
..certainly, growers and horticulturalists take note, the narrow phyllode forms of A. acuminata seem (from multiple anecdotal/underground sources) to be very consistent..and the particular specimen tested has about the 'cleanest' dmt profile of a plant i've seen, hence it is a potential reference if the reliability bares out..it should tolerate down to about Minus 8 degrees C, maybe down to minus 10 as some australian species growing in Europe can handle..
.
ps. regarding Growpen's non-dmt alkaloid from the acacia which isn't acuminata (on p24 #479)..by checking for lists of colour reactions to reagents, we can have aguess at the class of alkaloid..for instance, with Ehrlich's i believe PEAs turn yellow-green..tryptamines blue-purple..also, Growpen..the acuminata narrow leaf pictured p28 here does display a slight curving or bent tendency of some phyllodes, though not as actutely curved as the 'typical variant' of A. acuminata, which is really what has been referred to earlier as a 'Species Complex'..
..enlightening research and study, all 'acacia-loving-nexians', to borrow Spice Sailor's phrase..

.
below, Masai men's ceremony, with Acacia nilotica (and orally active brew)..
Attachments
Success with the iteaphylla it seems. evapped and was left with crystas+oils.. will defat and bioassay soon
^..exciting bricklaya..great initiative..look forawrd to hearing more..
and all's groovy cave paintings..i'll have a closer look at those species when i get time, soon..good to have an interested acacia researcher in the USA..

and all's groovy cave paintings..i'll have a closer look at those species when i get time, soon..good to have an interested acacia researcher in the USA..

cave paintings
Rising Star
Gowpen, I looked through those four species and I don't believe they are what I have near me. The phyllodes are too small on all of them. Thanks for helping out though! As you said, putting the puzzle pieces together on these species and plants in general is really half the fun and fascinating.
Acacias are truly popping every where I go, I am starting to get a good feel for the habitat of the ones I have seen around here and can begin predicting where I will see one before I even go there. I still need to look into native acacias in my area however as I believe most of the acacias I have seen growing are weeds though I could definitely be wrong.
I believe the first one may possibly be a.cyclops, or a.retinodes(provincialis?).
The second acacia is beyond me still!
A test extraction is in progress on a small branch of the second acacia.
Acacias are truly popping every where I go, I am starting to get a good feel for the habitat of the ones I have seen around here and can begin predicting where I will see one before I even go there. I still need to look into native acacias in my area however as I believe most of the acacias I have seen growing are weeds though I could definitely be wrong.
I believe the first one may possibly be a.cyclops, or a.retinodes(provincialis?).
The second acacia is beyond me still!
A test extraction is in progress on a small branch of the second acacia.
Well my test extraction have just 'Blown' me away...... (Metaphorically that is).
I now have some beautiful crystals sitting in a sea of clear and VERY sticky stuff.....
Question, how do I seperate the crystals from the sticky stuff, hahahaha fun fun fun...
These crystals do look like DMT and as this will be my first successful extrac so I am ecstatic....
I now have some beautiful crystals sitting in a sea of clear and VERY sticky stuff.....
Question, how do I seperate the crystals from the sticky stuff, hahahaha fun fun fun...
These crystals do look like DMT and as this will be my first successful extrac so I am ecstatic....
Attachments
the sticky stuff is probly DMT as well..or oxides..either way highly active..I would try to crystalize it all toegether for yellower xtals..but that is just me I like the yellow or orange DMT.
You can rextal in naptha or something if you want them cleaner.
You can smear some inactive leaf all over the sticky part if you want or dissolve it in iso after you collect the xtals and then evap it onto some leaf to test. I bet it is good.
You can rextal in naptha or something if you want them cleaner.
You can smear some inactive leaf all over the sticky part if you want or dissolve it in iso after you collect the xtals and then evap it onto some leaf to test. I bet it is good.
Thanks Jamie, not sure where to get iso (chemist ?).... it will be next weekend until I can try it and get my headspace nice and smooth...jamie said:the sticky stuff is probly DMT as well..or oxides..either way highly active..I would try to crystalize it all toegether for yellower xtals..but that is just me I like the yellow or orange DMT.
You can rextal in naptha or something if you want them cleaner.
You can smear some inactive leaf all over the sticky part if you want or dissolve it in iso after you collect the xtals and then evap it onto some leaf to test. I bet it is good.
I used 127 gms of Phyllodes and this is the first pull, I will do all the neccessary steps and report final yield.
White vinegar as acid cooks, NaOH and Shellite to pull.
..Growpen wrote:
to get rid of any not beneficial sticky stuff do the salty NaOH+H20 solvent wash described earlier..
many people rate 'orange wax' (quite sticky) as better than crystal..have a read of the various 'Jungle Spice' Alkaloids threads in the Nexus for different forms of MHRB, incl. 'Jim Jam' - all usually perfectly ok..
maybe the plant has good reason to put these other alks in there..
this also applies to bricklaya's 'crystal+oil' report ealier..if the oil is an alkaloid (eg ßcarb) it will not be 'defatted'..BTW, the solution must be acidic to defat, or you'll pull alkaloids..
cave paintings, will get on to that species ID in a few more days..
keep up the fascinating work all..
..like jamie said, there are other perfectly ok alks which are the 'sticky stuff'..NMT, oxide, betacarbs..sometimes (as with NMT) it can eventually solidify/crystalize after a few weeks..Question, how do I seperate the crystals from the sticky stuff, hahahaha fun fun fun...
to get rid of any not beneficial sticky stuff do the salty NaOH+H20 solvent wash described earlier..
many people rate 'orange wax' (quite sticky) as better than crystal..have a read of the various 'Jungle Spice' Alkaloids threads in the Nexus for different forms of MHRB, incl. 'Jim Jam' - all usually perfectly ok..
maybe the plant has good reason to put these other alks in there..
this also applies to bricklaya's 'crystal+oil' report ealier..if the oil is an alkaloid (eg ßcarb) it will not be 'defatted'..BTW, the solution must be acidic to defat, or you'll pull alkaloids..
cave paintings, will get on to that species ID in a few more days..
keep up the fascinating work all..
After holding the dish upside down over some dark paper I touched the white crystal and they fell to the paper. For the second pull I will not do this. So in effect I have 3 samples to test/bio. But I will see 'jungle' spice threads. oh so excited. I feel like a new-age lava lamp 

Similar threads
- Replies
- 0
- Views
- 257
- Replies
- 6
- Views
- 1K
- Replies
- 4
- Views
- 321
- Replies
- 2
- Views
- 230
- Replies
- 143
- Views
- 14K